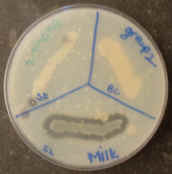

![]() |
Laboratory Investigations in Microbiology |
![]() |
Bacterial metabolism encompasses many steps necessary for bacteria to take in and utilize nutrients for growth, reproduction, and biosynthesis. Since this is a broad topic, let us begin with a brief overview of metabolism.
All chemical reactions that take place inside (and sometimes outside) a cell are termed its metabolism. This includes both the breakdown reactions of catabolism and the synthesis of compounds in anabolism. Like you and I, bacteria need food for its nutrients and its energy; unlike us, many bacteria can survive on very few basic nutrients, such as glucose. Whatever the food source for a bacterium may be, it needs to first be able to get the nutrients into the cell. Next, the nutrients need to be broken down partly or completely to get energy and precursor molecules. The energy is typically stored in a cell as ATP; the precursor molecules, meanwhile, are used up as the cell starts to build more bacterial cell components. Finally, energy and precursors are used up and the cell grows.
Bacteria that use organic molecules, such as sugars and proteins, as their source of carbon and energy are called heterotrophs. Like animals, heterotrophic bacteria "digest" their food to get energy from it. The most common nutrients used by bacteria are simple sugars (glucose, fructose), disaccharides (sucrose, lactose), complex carbohydrates (starch, glycogen), proteins, and lipids (triglycerides, fatty acids). To be able to use a particular nutrient, however, the bacterium must possess two things:
For example, most bacteria can use glucose, a very common nutrient, because they have all the enzymes (glycolytic pathway) to metabolize it and possess the membrane proteins needed to carry it into the cell. However, few bacteria can utilize starch as a nutrient. Starch is nothing more than a long chain of glucose molecules, but the same bacteria that use glucose freely often cannot use starch at all. Those bacteria that want to make use of starch as a food source must have the enzyme alpha amylase. Amylase hydrolyzes (breaks down a molecule using H2O) starch into shorter chains of glucose (dextrins) and individual glucose molecules.
Other bacteria have all the enzymes to break down citrate (e.g. in the Krebs cycle) but lack a membrane transporter called citrate permease. These bacteria would also not grow with citrate as their only food source.
Unfortunately, in nature most food sources do not come 'ready to eat'. Proteins, lipids, and complex carbohydrates are present (e.g. decaying plant matter) but cannot be absorbed by the cell as food. Such larger molecules are often called macromolecules - consisting of chains or complexes of many individual subunits. Starch and glycogen are chains of glucose molecules. Triglycerides are a complex of three fatty acids joined to a glycerol molecule. Proteins are chains of amino acids. macromolecules are too large to cross the plasma membrane of cells and thus must first be broken down into their monomers before they can be of use. [Eukaryotes can also engulf the macromolecules by phagocytosis and then complete the digestion process inside their lysosomes]
Whether or not a bacterium can break down a macromolecule depends on whether or not it produces the necessary enzyme. In order to break down starch, bacteria must make amylase. To break down proteins, bacteria must have proteases (such as caseinase or gelatinase). Lipases are required for bacteria to break down triglycerides.
We can determine if a bacterium has the ability to hydrolyze a macromolecule by adding this molecule to the culture medium. Since macromolecules are fairly large, they can often be seen (or made visible) in the agar. When a bacterium breaks down the macromolecule, we can also see it 'disappear' from the agar. The objective of this lab exercise is to determine the ability of six different bacteria to break down such macromolecules as starch, DNA, and protein (casein or gelatin).
Gelatinase test (Atlas p. 54): When
collagen is boiled, gelatin is produced. Gelatin is a protein th
at
solidifies at room temperature, but is liquid at 35C. Gelatin (collagen), of
course, is a major component of connective tissue in animals, forming a
defensive barrier between the outer layers of skin and the body's interior.
Pathogenic bacteria sometimes produce an enzyme to break down (hydrolyze) this
protein, allowing them to spread further in the body they infected. Like DNAse,
gelatinase is a virulence factor that makes the bacteria more harmful. We can
test for the presence of gelatinase by incubating bacteria in a gelatin deep.
During incubation, the gelatin melts, forming a liquid for bacterial growth. If
bacteria hydrolyze the gelatin, producing amino acids, the protein can no longer
gel when cooled down. A gelatin deep that remains liquid after cooling down
indicates a positive test for gelatinase (EA). If the deep hardens again
after cooling, the test is negative (EC, PV).

ropriate section.
Obtain
a DNA agar plate. Divide it into 3 sections as shown.
Next week
© 2003 - 2019 José de Ondarza, Ph.D.